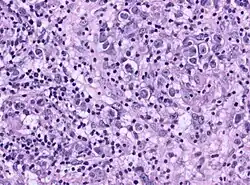

Germinom
Bei einem Germinom handelt es sich um einen Keimzelltumor des Zentralnervensystems (ZNS). Seine Histologie entspricht dem Dysgerminom in den Ovarien und dem Seminom des Hodens. Über 75 % der Patienten sind bei der Diagnosestellung zwischen 10 und 20 Jahre alt. Der Tumor spricht in der Regel sehr gut auf eine Strahlen- bzw. Chemotherapie an.
Prognose
Die 5-Jahres-Überlebensrate beträgt 90 %.[1]
Diagnostik
In weit über 80 % befindet sich der Tumor in der Mittellinie im Bereich der Pinealis, allerdings können bis zu 5 % der Tumore multifokal auftreten.[2] Die Diagnose wird meistens durch eine Biopsie gestellt. Auch die Bestimmung von beta-HCG und AFP im Liquor cerebrospinalis ist wegweisend.
Histologie
Das Germinom zeichnet sich durch ein flächenhaftes kohäsives Wachstum aus. Die großen Tumorzellen mit klarem Zytoplasma weisen oft prominente Nukleolen auf und werden durch Septen in Läppchen unterteilt. Diese Septen sind meist durch zahlreiche Lymphozyten ausgefüllt. Bei einem seltenen, aber prognostisch ungünstigem Subtyp werden auch Syncytiotrophoblasten (beta-HCG positiv) beobachtet. Immunhistochemisch lassen sich die Tumorzellen durch ihre Expression von plazentarer alkalischer Phosphatase (PLAP), C-Kit, Oct-4 und in seltenen Fällen Zytokeratin identifizieren.
Behandlung
Eine kombinierte Strahlentherapie und Chemotherapie mit Carboplatin, Etoposid oder Bleomycin ist kurativ.[3][4]
Einzelnachweise
- ↑ R. J. Packer, B. H. Cohen, K. Cooney, K. Coney: Intracranial germ cell tumors. In: Oncologist. Band 5, Nr. 4, 2000, S. 312–320, PMID 10964999 (alphamedpress.org).
- ↑ D. Keene, D. Johnston, D. Strother et al.: Epidemiological survey of central nervous system germ cell tumors in Canadian children. In: J. Neurooncol. Band 82, Nr. 3, 2007, S. 289–295, doi:10.1007/s11060-006-9282-2, PMID 17120159.
- ↑ T. Ueba, K. Yamashita, L. Fujisawa et al.: Long-term follow-up of 5 patients with intracranial germinoma initially treated by chemotherapy alone. In: Acta Neurochirurgica. Band 149, Nr. 9, 2007, S. 897–902; discussion 902, doi:10.1007/s00701-007-1268-0, PMID 17690837.
- ↑ C. Balmaceda, G. Heller, M. Rosenblum et al.: Chemotherapy without irradiation--a novel approach for newly diagnosed CNS germ cell tumors: results of an international cooperative trial. The First International Central Nervous System Germ Cell Tumor Study. In: J. Clin. Oncol. Band 14, Nr. 11, 1996, S. 2908–2915, PMID 8918487.